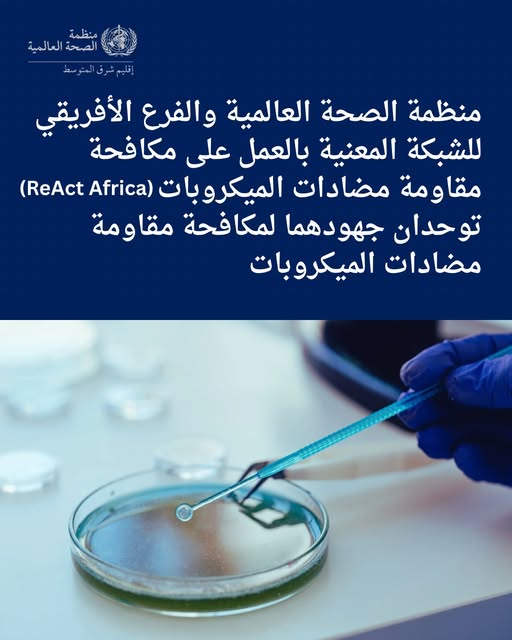
مقاومة مضادات الميكروبات

قالت منظمة الصحة العالمية، إن مقاومة مضادات الميكروبات تهدد بتقويض عقود من التقدم المحرز في علاج الأمراض المُعدية، وتعزيزا للاستجابة الإقليمية والعالمية لمقاومة مضادات الميكروبات.
مقاومة مضادات الميكروبات
وَقَّعَ المكتب الإقليمي لمنظمة الصحة العالمية لشرق المتوسط والفرع الأفريقي للشبكة المعنية بالعمل على مكافحة مقاومة مضادات الميكروبات مذكرة تفاهم ستعمل على:
1.دعم خطط العمل الوطنية لمقاومة مضادات الميكروبات
2.تعزيز حوكمة مقاومة مضادات الميكروبات والتنسيق المتعدد القطاعات
3.تعزيز الإشراف على مضادات الميكروبات والوقاية من العدوى ومكافحتها في مرافق الرعاية الصحية الأولية
4.النهوض بحملات التوعية وتغيير السلوك والإبلاغ عن المخاطر والمشاركة المجتمعية
5.تيسير تبادل المعارف، والبعثات التقنية المشتركة، والحوارات الإقليمية بشأن السياسات
6.الدعوة إلى الإتاحة المنصفة لوسائل التشخيص ومضادات الميكروبات ومصادر بناء القدرات.












